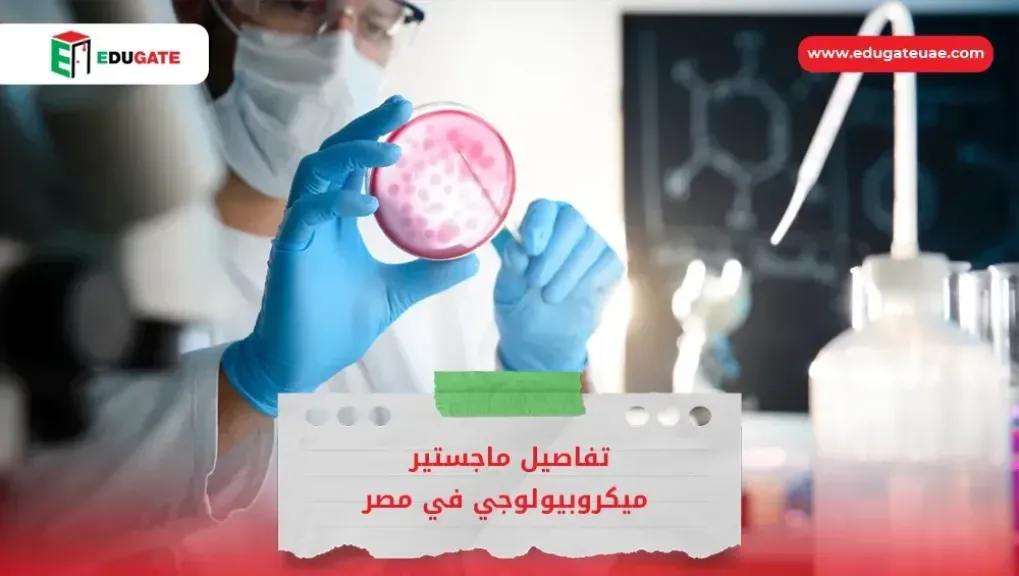
أنا حوا

تكلفة البورد في مصر للوافدين

يتجه العديد من الأطباء نحو دراسة البورد العربي، كونه أحد أبرز الشهادات الأكاديمية المهنية التي تساهم في تطوير الكفاءات الطبية بمختلف التخصصات. يمثل البورد خيارًا مثاليًا للأطباء الذين يسعون للتميز والتخصص في مجالاتهم، إذ يجمع بين المعرفة النظرية والتدريب العملي، مما يُكسب الطبيب خبرة مهنية شاملة تؤهله للعمل في المستشفيات داخل العالم العربي وخارجه.
يهدف برنامج البورد العربي إلى إعداد كوادر طبية متخصصة وفقًا لأعلى المعايير الدولية، من خلال مناهج دراسية متكاملة تشمل أحدث التطورات في العلوم الطبية. كما تُحدث المناهج بانتظام لتواكب التغيرات السريعة في أساليب التشخيص والعلاج، وتساعد الأطباء على الاطلاع المستمر على أحدث التقنيات والممارسات الطبية الحديثة.
تعرف على تكلفة البورد في مصر للوافدين
تعد تكلفة البورد العربي في مصر مناسبة مقارنة بقيمة التدريب والخبرة المكتسبة. وتختلف الرسوم حسب التخصص ومستوى البرنامج، وتشمل ما يلي:
-
رسوم التسجيل للاختصاص الرئيسي: حوالي 300 دولار أمريكي.
-
رسوم التسجيل للاختصاص الدقيق: حوالي 500 دولار أمريكي.
-
الرسوم السنوية: حوالي 500 دولار أمريكي.
-
وثائق التخرج: 100 دولار أمريكي.
-
تصديق الشهادات: 100 دولار أمريكي.
-
تقييم البحث العلمي: حوالي 250 دولار أمريكي.
تُسدد هذه الرسوم وفقًا للوائح المجلس العربي، مع إمكانية الدفع عبر الجامعات أو المراكز التدريبية المعتمدة في مصر.
شروط التسجيل في البورد العربي للطلاب الوافدين
يُشرف المجلس العربي للاختصاصات الصحية على تنظيم الدراسة ومنح شهادات البورد العربي، وهو الجهة الرسمية المعنية بتأهيل الأطباء في التخصصات الرئيسة والدقيقة، وتكون شروط البورد العربي في مصر كالتالي:
-
أن يكون الطبيب حاصلًا على شهادة البكالوريوس في الطب من جامعة معترف بها ومعتمدة.
-
أن يكون الطبيب قد أنهى فترة الامتياز بنجاح، وأن يكون لائقًا طبيًا لممارسة المهنة.
-
تقديم إثبات التسجيل في مركز تدريبي معتمد من المجلس العربي كمتدرب في أحد البرامج المتاحة.
-
تقديم ما يثبت حق مزاولة المهنة أو اجتياز اختبار الترخيص المهني.
-
تسديد الرسوم الدراسية المقررة للبورد العربي في مصر.
-
أن تكون جميع الوثائق الأكاديمية موثقة ومصدقة من الجهات الرسمية والسفارة المصرية في بلد المتقدم.
شروط القبول في الاختصاصات الدقيقة
يشترط أن يكون الطبيب قد حصل على شهادة البورد في الاختصاص الرئيسي، واجتاز الامتحان النهائي فيه مع إثبات التسجيل في مركز تدريب معتمد للتخصص الدقيق، واستيفاء متطلبات المهنة وفقًا للوائح المجلس العربي.
دراسة البورد العربي في مصر للطلاب الوافدين
-
يعتبر البورد العربي في مصر نظامًا تدريبيًا متكاملًا يشرف عليه المجلس العربي للاختصاصات الصحية، ويهدف إلى رفع كفاءة الأطباء في مختلف المجالات الطبية.
-
يركز البرنامج على الجمع بين الدراسة النظرية والتدريب العملي المكثف داخل المستشفيات الجامعية والمراكز المعتمدة.
-
تساهم دراسة البورد العربي في مصر في تعزيز مهارات الأطباء وتمكينهم من التعامل مع التقنيات الحديثة في التشخيص والعلاج، مما يفتح لهم آفاقًا واسعة للعمل داخل مصر أو في الدول العربية.
-
تشمل المناهج موادًا متقدمة في الطب السريري، والطب الوقائي، والإدارة الصحية، إلى جانب التدريب باستخدام تقنيات المحاكاة الطبية المتطورة والأجهزة الحديثة في المختبرات.
-
يمنح المتدربون فرصة التدريب العملي على إجراء الفحوصات والتحاليل الطبية باستخدام أحدث الأجهزة المعملية، مع إشراف مباشر من أساتذة متخصصين.
-
بهذا، تضمن دراسة البورد العربي في مصر بيئة علمية متكاملة تجمع بين الخبرة النظرية والتطبيق العملي، بما يواكب التطورات العالمية في التعليم الطبي.
الخاتمة
يعد البورد العربي أحد أهم المسارات الأكاديمية للأطباء الراغبين في تطوير مهاراتهم وتحقيق التميز المهني في مجالات الطب المختلفة وتُوفر مصر من خلال جامعاتها ومراكزها المعتمدة، بيئة تدريبية متكاملة تجمع بين التعليم النظري والعملي كما يسهم مكتب إيديوجيت في تسهيل إجراءات التسجيل والتقديم، مما يجعل دراسة البورد العربي في مصر فرصة حقيقية للطبيب الذي يسعى لمستقبل مهني متميز واعتراف مهني عربي ودولي.








